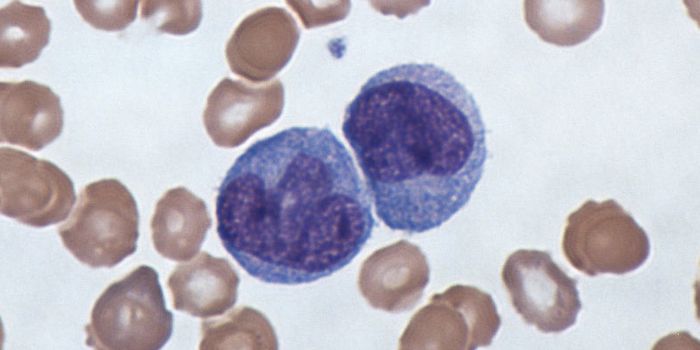
Genes Have an Influence on our Response to Infection

T-Cells
T-Cells: A type of white blood cell that plays an important role in the immune system. They are produced by the thymus gland and help the body fight off viruses, bacteria, and parasites.
-
AUG 30, 2017CardiologyBlood vessels are the roads and highways of the cardiovascular system, carrying oxygenated blood cells, nutrients, and i ...Written By: Kara MarkerAUG 29, 2017CancerIt’s no secret that obesity is a risk factor for several health conditions, including cancer. But specific to canc ...AUG 29, 2017CardiologyHeart disease is one of those health problems that stems from a complicated mixture of factors. Preventing heart disease ...Written By: Kara MarkerAUG 29, 2017Cell & Molecular BiologyCats have been traveling with people for thousands of years, carried by mariners, farmers and Vikings.Written By: Carmen LeitchAUG 28, 2017VideosIn this video from the Koch Institute at MIT, you can see work that won an Image Award for 2017. The image was generated ...Written By: Carmen LeitchAUG 28, 2017CancerThe US safety agency announced a more stringent oversight on stem-cell clinics to prevent the use of unapproved treatmen ...AUG 27, 2017MicrobiologyWith all the talk of the human microbiome, it’s worth pointing out that other organisms- even teeny tiny ones - ha ...Written By: Kerry EvansAUG 26, 2017Cell & Molecular BiologyResearchers created a phase diagram to describe how the components of a cell experience the cytoplasm in which they are ...Written By: Carmen LeitchAUG 26, 2017ImmunologyThe body can’t make omega-3 fatty acids on its own, which is why nutrition scientists stress the importance of obt ...Written By: Kara MarkerAUG 24, 2017MicrobiologyScientists are learning more about the specialized microbiomes of elite athletes.Written By: Carmen LeitchAUG 23, 2017CardiologySelf-driving cars? How about self-healing heart cells? For a while scientists have been looking for ways to help heart c ...Written By: Kara MarkerAUG 23, 2017VideosWarts are unsightly and sometimes even painful. We typically associate warts with disease and contagion, a belief perpet ...AUG 22, 2017ImmunologyEver since penicillin was discovered in 1928, bacteria have been fighting back against every single antibiotic we develo ...Written By: Kara MarkerAUG 22, 2017Plants & AnimalsClimate change is a major concern for environmentalists; one of the things they do is try to protect wildlife from succu ...Written By: Anthony BouchardAUG 22, 2017CancerA relatively recent class of cancer drugs may be more potent than scientists thought, having both the capacity to stop c ...AUG 21, 2017ImmunologyWe often think of antibodies and vaccines when we talk about viral infection, but there’s another part of the immu ...Written By: Kara MarkerAUG 20, 2017ImmunologyThe body can go into “shock” for several different reasons, but it’s never a good sign. Whatever the s ...Written By: Kara MarkerAUG 16, 2017CardiologyHeart attack patients can be given regenerative tissue to help them recover, but the current procedure involves open-hea ...Written By: Kara MarkerAUG 16, 2017Cell & Molecular BiologyWhen an infectious illness sickens multiple people, they often respond in different ways; researchers have shown genes u ...Written By: Carmen LeitchAUG 16, 2017MicrobiologyResearchers at the National Institute of Allergy and Infectious Disease knew that some viruses - herpes simplex virus, f ...Written By: Kerry EvansAUG 16, 2017ImmunologyA vaccine for yellow fever was first developed in 1937, using a strain of the yellow fever virus that was just a few ami ...Written By: Kara MarkerAUG 16, 2017CancerA protein from the “shaggy ink cap” mushroom may be a lethal fighter against leukemia cells, scientists repo ...AUG 15, 2017Clinical & Molecular DXAn estimated 7.9 million babies are born every year with birth defects. In efforts to understand the causes of these def ...AUG 14, 2017Cell & Molecular BiologyCures are extremely rare in medicine, so news that scientists are attempting a functional cure for type 1 diabetes has g ...Written By: Carmen Leitch
AUG 30, 2017
Cardiology
Blood vessels are the roads and highways of the cardiovascular system, carrying oxygenated blood cells, nutrients, and i
...
Written By:
Kara Marker
AUG 29, 2017
Cancer
It’s no secret that obesity is a risk factor for several health conditions, including cancer. But specific to canc
...
AUG 29, 2017
Cardiology
Heart disease is one of those health problems that stems from a complicated mixture of factors. Preventing heart disease
...
Written By:
Kara Marker
AUG 29, 2017
Cell & Molecular Biology
Cats have been traveling with people for thousands of years, carried by mariners, farmers and Vikings.
Written By:
Carmen Leitch
AUG 28, 2017
Videos
In this video from the Koch Institute at MIT, you can see work that won an Image Award for 2017. The image was generated
...
Written By:
Carmen Leitch
AUG 28, 2017
Cancer
The US safety agency announced a more stringent oversight on stem-cell clinics to prevent the use of unapproved treatmen
...
AUG 27, 2017
Microbiology
With all the talk of the human microbiome, it’s worth pointing out that other organisms- even teeny tiny ones - ha
...
Written By:
Kerry Evans
AUG 26, 2017
Cell & Molecular Biology
Researchers created a phase diagram to describe how the components of a cell experience the cytoplasm in which they are
...
Written By:
Carmen Leitch
AUG 26, 2017
Immunology
The body can’t make omega-3 fatty acids on its own, which is why nutrition scientists stress the importance of obt
...
Written By:
Kara Marker
AUG 24, 2017
Microbiology
Scientists are learning more about the specialized microbiomes of elite athletes.
Written By:
Carmen Leitch
AUG 23, 2017
Cardiology
Self-driving cars? How about self-healing heart cells? For a while scientists have been looking for ways to help heart c
...
Written By:
Kara Marker
AUG 23, 2017
Videos
Warts are unsightly and sometimes even painful. We typically associate warts with disease and contagion, a belief perpet
...
AUG 22, 2017
Immunology
Ever since penicillin was discovered in 1928, bacteria have been fighting back against every single antibiotic we develo
...
Written By:
Kara Marker
AUG 22, 2017
Plants & Animals
Climate change is a major concern for environmentalists; one of the things they do is try to protect wildlife from succu
...
Written By:
Anthony Bouchard
AUG 22, 2017
Cancer
A relatively recent class of cancer drugs may be more potent than scientists thought, having both the capacity to stop c
...
AUG 21, 2017
Immunology
We often think of antibodies and vaccines when we talk about viral infection, but there’s another part of the immu
...
Written By:
Kara Marker
AUG 20, 2017
Immunology
The body can go into “shock” for several different reasons, but it’s never a good sign. Whatever the s
...
Written By:
Kara Marker
AUG 16, 2017
Cardiology
Heart attack patients can be given regenerative tissue to help them recover, but the current procedure involves open-hea
...
Written By:
Kara Marker
AUG 16, 2017
Cell & Molecular Biology
When an infectious illness sickens multiple people, they often respond in different ways; researchers have shown genes u
...
Written By:
Carmen Leitch
AUG 16, 2017
Microbiology
Researchers at the National Institute of Allergy and Infectious Disease knew that some viruses - herpes simplex virus, f
...
Written By:
Kerry Evans
AUG 16, 2017
Immunology
A vaccine for yellow fever was first developed in 1937, using a strain of the yellow fever virus that was just a few ami
...
Written By:
Kara Marker
AUG 16, 2017
Cancer
A protein from the “shaggy ink cap” mushroom may be a lethal fighter against leukemia cells, scientists repo
...
AUG 15, 2017
Clinical & Molecular DX
An estimated 7.9 million babies are born every year with birth defects. In efforts to understand the causes of these def
...
AUG 14, 2017
Cell & Molecular Biology
Cures are extremely rare in medicine, so news that scientists are attempting a functional cure for type 1 diabetes has g
...
Written By:
Carmen Leitch